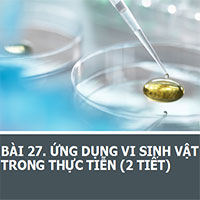
PowerPoint Sinh học 10 Bài 27: Ứng dụng vi sinh vật trong thực tiễn

giăng
-

PowerPoint Tiếng Việt 3 Bài 10: Viết đoạn văn nêu tình cảm, cảm xúc với người mà em yêu quý
Giáo án Tiếng Việt 3 Kết nối tri thức (Word + PPT)
Giáo án PowerPoint Tiếng Việt 3 Kết nối Bài 10 Luyện tập: Viết đoạn văn nêu tình cảm, cảm xúc với người mà em yêu quý gồm file PPT và Word giúp giáo viên soạn giáo án điện tử hay và sinh động hơn.
32
-

PowerPoint Ngữ Văn 8 Bài 9: Thảo luận về một vấn đề trong đời sống phù hợp với lứa tuổi
Giáo án Ngữ Văn 8 Kết nối tri thức (Word + PPT)
Mẫu kế hoạch bài dạy Ngữ Văn 8 Bài 9: Thảo luận về một vấn đề trong đời sống phù hợp với lứa tuổi sách KNTT được các thầy cô giáo biên soạn theo chương trình giáo dục phổ thông mới nhất được Hoatieu chia sẻ trong bài viết sau đây sẽ giúp các thầy cô tiết kiệm được thời gian khi soạn giáo án.
30
-

PowerPoint Ngữ Văn 8 Bài 9: Viết văn bản kiến nghị về một vấn đề của đời sống
Giáo án Ngữ Văn 8 Kết nối tri thức (Word + PPT)
Mời các thầy cô tải giáo án PowerPoint Ngữ Văn 8 Bài 9: Viết văn bản kiến nghị về một vấn đề của đời sống sách CTST file PPT và Word tại bài viết này của HoaTieu.vn để thuận tiện cho việc tham khảo và điều chỉnh nội dung phù hợp với tình hình giảng dạy tại địa phương.
27
-

PowerPoint Tiếng Việt 4 Bài 8: Luyện tập viết đoạn văn nêu lí do thích một câu chuyện
Giáo án Tiếng Việt 4 Chân trời sáng tạo (Word + PPT)
Giáo án Powerpoint Tiếng Việt 4 Chân trời sáng tạo Bài 8: Luyện tập viết đoạn văn nêu lí do thích một câu chuyện gồm file PPT và Word có hình ảnh đẹp mắt, dễ dàng chỉnh sửa, hỗ trợ giáo viên soạn giáo án điện tử nhanh chóng và tiết kiệm thời gian.
26
-

PowerPoint Tiếng Việt 3 Bài 10: Từ chỉ đặc điểm, câu nêu đặc điểm
Giáo án Tiếng Việt 3 Kết nối tri thức (Word + PPT)
Giáo án PowerPoint Tiếng Việt 3 Kết nối tri thức Bài 10 Luyện tập: Từ ngữ chỉ đặc điểm, câu nêu đặc điểm gồm file PPT và Word giúp giáo viên soạn giáo án điện tử hay và sinh động hơn.
26
-

PowerPoint Sinh học 10 Bài 11: Vận chuyển các chất qua màng sinh chất
Giáo án Sinh học 10 Chân trời sáng tạo (PPT)
Mời thầy cô tải file PPT giáo án PowerPoint Sinh học 10 Bài 11: Vận chuyển các chất qua màng sinh chất trong bài viết dưới đây của HoaTieu.vn để phục vụ công tác soạn giáo án dễ dàng, thuận tiện.
14
-

PowerPoint Ngữ Văn 8 Bài 8: Viết bài văn phân tích một tác phẩm truyện
Giáo án Ngữ Văn 8 Kết nối tri thức (Word + PPT)
Mẫu giáo án PowerPoint Ngữ Văn 8 Bài 8: Viết bài văn phân tích một tác phẩm truyện của bộ sách Kết nối tri thức dưới đây sẽ là tài liệu tham khảo bổ ích giúp các thầy cô tiết kiệm thời gian khi soạn giáo án theo chương trình giáo dục phổ thông mới.
14
-

PowerPoint Đạo đức 5 Bài 4: Em nhận biết khó khăn trong học tập và cuộc sống
Giáo án Đạo đức lớp 5 Chân trời sáng tạo (Word + PPT)
PowerPoint Đạo đức 5 Bài 4: Em nhận biết khó khăn trong học tập và cuộc sống sách Chân trời sáng tạo gồm file trình chiếu PPT và Word có hiệu ứng sinh động, giúp giáo viên soạn giáo án điện tử hay và hấp dẫn hơn.
11
-

PowerPoint Tiếng Việt 4 Bài 2: Quan sát, tìm ý cho bài văn miêu tả cây cối
Giáo án Tiếng Việt 4 Chân trời sáng tạo (Word + PPT)
Giáo án Powerpoint Tiếng Việt 4 Chân trời sáng tạo Bài 2: Quan sát, tìm ý cho bài văn miêu tả cây cối gồm file PPT và Word có hình ảnh đẹp mắt, dễ dàng chỉnh sửa, hỗ trợ giáo viên soạn giáo án điện tử nhanh chóng và tiết kiệm thời gian.
10
-

PowerPoint Khoa học 4 Bài 18: Ôn tập chủ đề Thực vật và động vật
Giáo án Khoa học 4 Kết nối tri thức (Word + PPT)
PowerPoint Khoa học 4 Bài 18: Ôn tập chủ đề Thực vật và động vật sách Kết nối tri thức kèm theo mẫu giáo án file word, hỗ trợ giáo viên soạn giáo án điện tử trình chiếu ppt tiết kiệm thời gian và công sức hơn.
8
-

PowerPoint Tiếng Việt 4 Chân trời sáng tạo Ôn tập giữa kì 1 Tiết 6+7
Giáo án Tiếng Việt 4 Chân trời sáng tạo (Word + PPT)
Giáo án PowerPoint Tiếng Việt 4 Ôn tập giữa kì 1 Tiết 6+7 sách Chân trời sáng tạo gồm file trình chiếu PPT và Word có hình ảnh đẹp mắt, dễ dàng chỉnh sửa.
8
-

PowerPoint Đạo đức 5 Bài 3: Em tôn trọng sự khác biệt của người khác
Giáo án Đạo đức lớp 5 Chân trời sáng tạo (Word + PPT)
PowerPoint Đạo đức 5 Bài 3: Em tôn trọng sự khác biệt của người khác sách Chân trời sáng tạo gồm file trình chiếu PPT và Word có hiệu ứng sinh động, giúp giáo viên soạn giáo án điện tử hay và hấp dẫn hơn.
8
-

PowerPoint Sinh học 10 Bài 14: Thực hành: Một số thí nghiệm về enzyme
Giáo án Sinh học 10 Chân trời sáng tạo (PPT)
Hoatieu.vn xin giới thiệu giáo án PowerPoint Sinh học 10 Bài 14: Thực hành: Một số thí nghiệm về enzyme. Tài liệu này được biên soạn công phu, bám sát chương trình SGK, có hướng dẫn thao tác chi tiết, giúp bài giảng Sinh học 10 thêm sinh động.
6
-

PowerPoint Sinh học 10 Bài 12: Thực hành: Sự vận chuyển các chất qua màng sinh chất
Giáo án Sinh học 10 Chân trời sáng tạo (PPT)
Giáo án PowerPoint Sinh học 10 Bài 12: Thực hành: Sự vận chuyển các chất qua màng sinh chất sẽ giúp thầy cô dạy Sinh hoc tiết kiệm thời gian, có ngay slide minh họa bài giảng bằng phần mềm đầy đủ, dễ chỉnh sửa.
5
-

PowerPoint Sinh học 10 Bài 26: Công nghệ vi sinh vật
Giáo án Sinh học 10 Chân trời sáng tạo (PPT)
Đây là giáo án điện tử Sinh học 10 Bài 26: Công nghệ vi sinh vật được trình bày trên phần mềm PowerPoint, sẽ rất thuận tiện cho thầy cô trong quá trình sử dụng, mời các thầy cô cùng tham khảo và tải về trong bài viết dưới đây.
3
-

PowerPoint Sinh học 10 Bài 30: Ứng dụng của virus trong y học và thực tiễn
Giáo án Sinh học 10 Chân trời sáng tạo (PPT)
Trong bài viết này Hoatieu xin chia sẻ đến quý thầy cô giáo án PowerPoint Sinh học 10 Bài 30: Ứng dụng của virus trong y học và thực tiễn sách CTST được trình bày dưới dạng PPT. Mời các thầy cô tải về tham khảo chỉnh sửa sao cho phù hợp với nội dung bài dạy.
3
-

PowerPoint Sinh học 10 Bài 19: Quá trình phân bào
Giáo án Sinh học 10 Chân trời sáng tạo (PPT)
Giáo án PowerPoint Sinh học 10 Bài 19: Quá trình phân bào được thiết kế dưới dạng file PPT đẹp mắt, giúp thầy cô dễ dàng xây dựng kế hoạch bài dạy môn Sinh học 10 Chân trời sáng tạo theo chương trình mới.
2
-

PowerPoint Tin học 10 Bài 22: Kiểu dữ liệu danh sách
Giáo án Tin học 10 Kết nối tri thức (Word+PPT)
Mẫu kế hoạch bài dạy Tin học 10 Bài 22: Kiểu dữ liệu danh sách sách KNTT được các thầy cô giáo biên soạn theo chương trình giáo dục phổ thông mới nhất được Hoatieu chia sẻ trong bài viết sau đây sẽ giúp các thầy cô tiết kiệm được thời gian và công sức khi soạn giáo án.
2
-

PowerPoint Sinh học 10 Bài Ôn tập chương 5
Giáo án Sinh học 10 Chân trời sáng tạo (PPT)
Bi viết sau đây là mẫu giáo án PowerPoint Sinh học 10 Bài Ôn tập chương 5 được biên soạn theo đúng hướng dẫn của Bộ Giáo dục, giúp các thầy cô giáo có thêm tài liệu tham khảo để biên soạn giáo án môn Sinh học tốt hơn.
1
-

PowerPoint Sinh học 10 Bài 10: Thực hành: Quan sát tế bào
Giáo án Sinh học 10 Chân trời sáng tạo (PPT)
Dưới đây là mẫu kế hoạch bài dạy Sinh học 10 Bài 10: Thực hành: Quan sát tế bào mới nhất. File giáo án môn Sinh học 10 được trình bày dưới dạng file PPT, sẽ giúp các thầy cô dễ dàng biên soạn và chỉnh sửa lại sao cho phù hợp với nội dung giáo dục của nhà trường.
1
-

PowerPoint Sinh học 10 Bài 27: Ứng dụng vi sinh vật trong thực tiễn
Giáo án Sinh học 10 Chân trời sáng tạo (PPT)
Giáo án PowerPoint Sinh học 10 Bài 27: Ứng dụng vi sinh vật trong thực tiễn với file PPT đầy đủ, bám sát nội dung chương trình sách giáo khoa sẽ là tài liệu tham khảo bổ ích cho các thầy cô trong công tác soạn giáo án cho năm học mới.